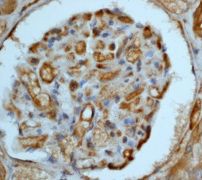

> Antigen, Antibodies, ELISA, Western Blot > Primary Antibody > Monoclonal Antibodies > IRS-4 Antibody (C-term)Brand |
Leading Biology | Catalog Number |
APR08042G |
Product Type |
Monoclonal Antibodies | Field of Research |
|
Product Overview |
We constantly strive to ensure we provide our customers with the best antibodies. As a result of this work we offer this antibody in purified format.
We are in the process of updating our datasheets. If you have any questions regarding this update, please feel free to contact our technical support team.
This product is a high quality IRS-4 antibody (C-term).
|
||
Molecular Weight |
43541 Da
|
||
Cellular Localization |
Antigen Cellular Localization:
Membrane; Multi-pass membrane protein.
|
||
Host |
Rabbit
|
||
Species Reactivity |
Human
|
||
Target |
A synthetic peptide corresponding to residues on the C-terminus of human IRS-4 was used as an immunogen.
|
||
Clone |
EP907Y
|
||
GeneID |
|||
UniProt ID |
|||
Function |
This receptor is controlled by G proteins. Inward rectifier potassium channels are characterized by a greater tendency to allow potassium to flow into the cell rather than out of it. Their voltage dependence is regulated by the concentration of extracellular potassium; as external potassium is raised, the voltage range of the channel opening shifts to more positive voltages. The inward rectification is mainly due to the blockage of outward current by internal magnesium. Can be blocked by extracellular barium (By similarity). Subunit of ATP-sensitive potassium channels (KATP). Can form cardiac and smooth muscle-type KATP channels with ABCC9. KCNJ11 forms the channel pore while ABCC9 is required for activation and regulation.
|
||
Summary |
A new member of the IRS family, IRS-4, is a 160-kDa tyrosine kinase which phosphorylates cellular substrates when it is activated by the binding of insulin (1). IRS-4 was originally discovered in human embryonic kidney 293 cells. Subcellular fractionation revealed that about 50% of IRS-4 was located in cellular membranes, and immunofluorescence indicated that IRS-4 was concentrated at the plasma membrane. Immunoelectron microscopy conclusively established that a large portion of the IRS-4 was located at the cytoplasmic surface of the plasma membrane in both the unstimulated and insulin-treated states. IRS-4 was found to be associated with two src homology 2 (SH2) domain-containing proteins, phosphatidylinositol 3-kinase and Grb2, the adaptor to the guanine nucleotide exchange factor for Ras (2).
|
||
Form |
50 mM Tris-Glycine (pH 7.4), 0.15 M NaCl, 40% Glycerol, 0.01% sodium azide and 0.05% BSA. |
||
Storage & Stability |
Store at +4°C short term. For long-term storage, aliquot and store at -20°C or below. Stable for 12 months at -20°C. Avoid repeated freeze-thaw cycles.
|
||
Applications |
WB, IHC
|
||
Dilution |
WB~~1:1000~10000
IHC~~1:50~100
|
||
Synonyms |
ATP-sensitive inward rectifier potassium channel 11, IKATP, Inward rectifier K(+) channel Kir62, Potassium channel, inwardly rectifying subfamily J member 11, KCNJ11
|
||
Images |

A. Western blot analysis on 293 cell lysate using anti-IRS-4 RabMAb (Cat. APR08042G), dilution 1:5000.
B. Immunohistochemical staining of paraffin-embedded human kidney using anti-IRS-4 RabMAb (Cat. APR08042G). |
||
Specification |
|||
Quantity |
|
||
| Select | Brand | Catalog No. | Product Name | Pack Size | Type | Field of Research | Specification | Quantity | Price(USD) | |
| 1 | Leading Biology | APG02467G | CCK4 / PTK7 Antibody (clone 4F9) | 50 μl | Monoclonal Antibodies |
|
$495.00 | Add Ask | ||
| 2 | Leading Biology | AMM04683G | GALT Antibody (clone 4C11) | 50 μg | Monoclonal Antibodies |
|
$545.00 | Add Ask | ||
| 3 | Leading Biology | AMM01402G | Vimentin (Mesenchymal Cell Marker) Antibody - With BSA and Azide | 50 ug | Monoclonal Antibodies |
|
$395.00 | Add Ask | ||
| 4 | Leading Biology | APR08280G | LTA4H / LTA4 Antibody (clone 9G8) | 50 μl | Monoclonal Antibodies |
|
$495.00 | Add Ask | ||
| 5 | Leading Biology | AMM00172G | CD1a / HTA1 (Mature Langerhans Cells Marker) Antibody - With BSA and Azide | 50 ug | Monoclonal Antibodies |
|
$395.00 | Add Ask | ||
| 6 | Leading Biology | AMM05750G | CEBPA Antibody | 100 μl | Monoclonal Antibodies |
|
$545.00 | Add Ask |
 Leading Biology Inc.
2600 Hilltop DR, Building G, B Suite C138
Richmond, CA, 94806
Tel: 1-661-524(LBI)-0262
Email: info@leadingbiology.com
Leading Biology Inc.
2600 Hilltop DR, Building G, B Suite C138
Richmond, CA, 94806
Tel: 1-661-524(LBI)-0262
Email: info@leadingbiology.com
Complete this form and click send to ask us a question, request a quote or simply say hello.

You have 0 item in your cart

You have 0 item in your inquiry list
